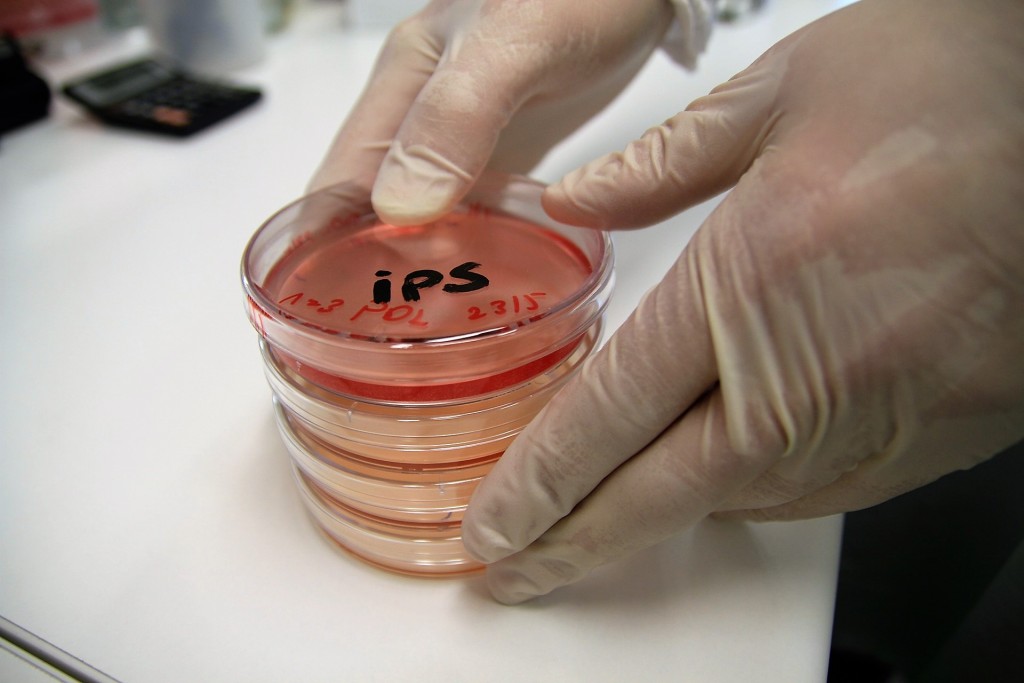

Científicos japoneses crean células iPS capaces de regenerar el miocardio
Podrían emplearse en pacientes que hayan sufrido fallos cardiacos. Los tests clínicos en seres humanos comenzarán en 2017.
TOKIO, Japón.- Un grupo de científicos nipones anunció hoy que desarrolló un método para cultivar células de pluripotencia inducida (iPS) capaces de regenerar el tejido muscular del corazón, una técnica que podría facilitar los trasplantes de miocardio.
El equipo de investigadores de la Universidad de Keio (Tokio) logró producir en laboratorio células similares a las del miocardio con una tasa de éxito del 90 por ciento, empleando un cultivo que reduce el riesgo de que éstas se reproduzcan de forma cancerosa.
Estas células iPS “de alta pureza”, hasta ahora sólo probadas en animales, comenzarán a emplearse en test clínicos el próximo año para garantizar que puedan implantarse de forma segura en pacientes humanos, informó el centro universitario en un comunicado.
El director de la investigación, Keiichi Fukuda, señaló que esta tecnología supone “un gran paso adelante” que hace posible la creación artificial de células del miocardio que podrían emplearse en pacientes que hayan sufrido fallos cardiacos.
Se espera que la aplicación clínica de las células iPS, que poseen la capacidad de convertirse en cualquier tipo celular especializado, pueda ampliar las posibilidades de los tratamientos regenerativos y suponga un importante avance hacia la medicina personalizada.
El pionero en generación de iPS, el japonés Shinya Yamanaka, fue galardonado en 2012 año con el Premio Nobel de Medicina por el método que desarrolló para crear este tipo de células mediante la reprogramación de células ya maduras.

